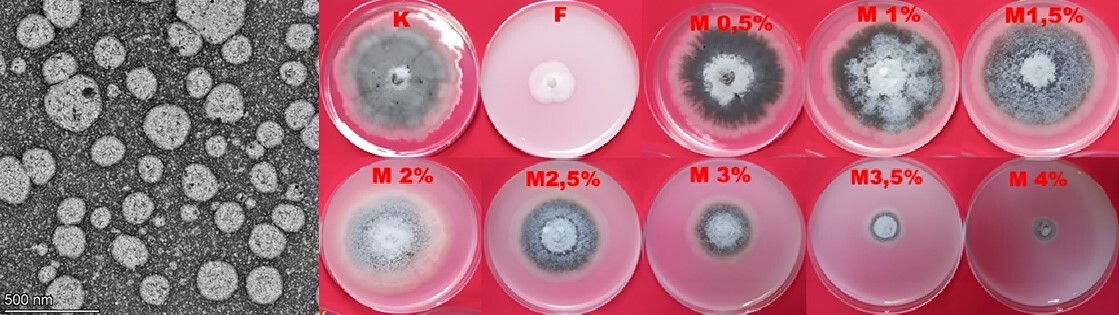

ORIGINAL ARTICLE
Formulation, In Vitro Antifungal Activity, and Safety Assessments of a Nano-Emulsion Fungicide Based on Neem Oil, Citronella, and Liquid Smoke Against Chili Anthracnose Diseases
1
Research Center for Estate Crops, National Research and Innovation Agency, Jl. Raya Jakarta-Bogor, 16911, Cibinong, Indonesia
2
Research Center for Horticulture, National Research and Innovation Agency, Jl. Raya Jakarta-Bogor, 16911, Cibinong, Indonesia
These authors had equal contribution to this work
A - Research concept and design; B - Collection and/or assembly of data; C - Data analysis and interpretation; D - Writing the article; E - Critical revision of the article; F - Final approval of article
Submission date: 2025-08-20
Acceptance date: 2026-03-09
Online publication date: 2026-03-23
Corresponding author
Melati Melati
Research Center for Estate Crops, National Research and Innovation Agency, Jl. Raya Jakarta-Bogor, 16911, Cibinong, Indonesia
Research Center for Estate Crops, National Research and Innovation Agency, Jl. Raya Jakarta-Bogor, 16911, Cibinong, Indonesia
HIGHLIGHTS
- Neem, citronella, and liquid smoke nano-emulsion posses antifungal activity
- Neem, citronella, and liquid smoke nano-emulsion offers eco-friendly fungicide option
- Neem, citronella, and liquid smoke nano-emulsion is environmentally friendly
KEYWORDS
TOPICS
ABSTRACT
Anthracnose, caused by Colletotrichum spp., is one of the major challenges in chili cultivation and is responsible for significant yield losses. This study aimed to develop a nano-emulsion fungicide formulation based on neem oil (Azadirachta indica), citronella oil (Cymbopogon nardus), and liquid smoke for controlling Colletotrichum capsici and Colletotrichum acutatum in vitro. The nano-emulsion was prepared using a high-speed homogenizer to achieve a droplet size below 250 nm. The formulations were characterized using Dynamic Light Scattering (DLS) and High-Resolution Transmission Electron Microscopy (HRTEM) to determine the optimal composition, while the chemical profile of the formulation was analyzed using Gas Chromatography–Mass Spectrometry (GC–MS). Safety assessments included phytotoxicity, ocular irritation, and acute oral and dermal toxicity tests. The optimal formulation, designated as MSA3, produced droplets with an average size of 240.1 nm and a low polydispersity index (PDI) of 0.155. In vitro antifungal assays revealed that at a 2.0% concentration, the nano-formulation (MSA3) was as effective as the commercial fungicide in controlling C. capsici, whereas significant inhibition of C. acutatum was observed only at concentrations above 4.0%. This formulation exhibited no phytotoxicity effects and improved chili seed germination by up to 20%. Oral toxicity assessment classified MSA3 as non-hazardous, while dermal exposure indicated a moderate hazard level. These results indicate that the nano-emulsion fungicide formulated with neem oil, citronella oil, and liquid smoke at this formulation holds considerable potential as an environmentally friendly alternative to conventional synthetic fungicides in sustainable agriculture.
CONFLICT OF INTEREST
The authors have declared that no conflict of interests exist.
We process personal data collected when visiting the website. The function of obtaining information about users and their behavior is carried out by voluntarily entered information in forms and saving cookies in end devices. Data, including cookies, are used to provide services, improve the user experience and to analyze the traffic in accordance with the Privacy policy. Data are also collected and processed by Google Analytics tool (more).
You can change cookies settings in your browser. Restricted use of cookies in the browser configuration may affect some functionalities of the website.
You can change cookies settings in your browser. Restricted use of cookies in the browser configuration may affect some functionalities of the website.